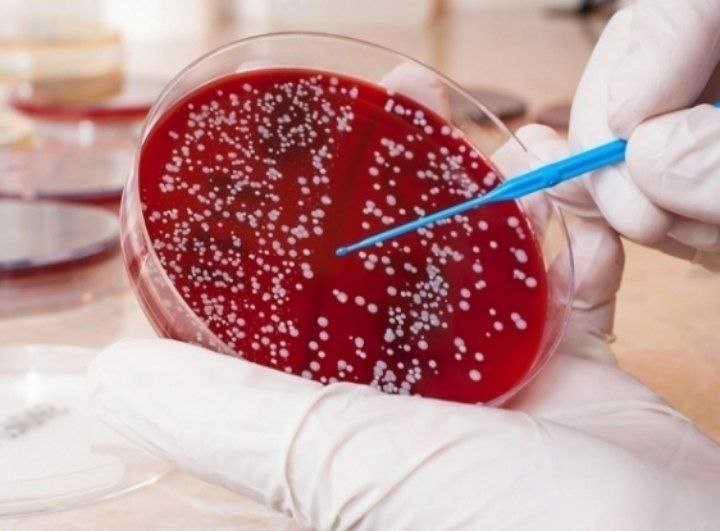

✅Ekzemaning endogen sabablari: -Hazm qilish buzilishlari (pankreatit,meteorizm,disbakterioz,gepatit) va evakuatsiyalar (ich qotishi,ich ketishi); -Buyrak disfunktsiyasi, nefrozlar; -Atopik kasalliklarga irsiy moyillik; -Angiovegetativ nevrozlar; -Neyroendokrin patologiyalar va boshqalar. ✅Ekzemaning ekzogen sabablari: -Neft mahsulotlari, kislotalar, spirtlar, fenollar va boshqa qo’zg’atuvchi xususiyatli agressiv va sintetik…

✔️Gripp va O‘RVI ✔️Yozda virusli infeksiyani yuqtirish qishga qaraganda 25 foiz osonroq, ammo shuni yodda tutish kerakki, yozgi viruslar O‘RVIning odatiy belgilaridan tashqari, qorin og‘rig‘i va ko‘ngil aynishiga ham sabab bo‘lishi mumkin bo‘lgan boshqa turdagi mikroblar tomonidan chaqiriladi. Ushbu viruslarga kamroq moyil bo‘lish uchun jismoniy tarbiya bilan faol shug‘ullanishingiz kerak. Albatta,…

📌Meningit — bosh va orqa miya pardalarining infeksiya tufayli kelib chiqadigan yallig‘lanishidir. Bu kasallik o‘z vaqtida tashxis qo‘yilmasa va davolanmasa, jiddiy asoratlarga va hatto o‘limga olib kelishi mumkin. 📌Meningit belgilari quyidagilarni o‘z ichiga oladi: 📌Kuchli bosh og‘rig‘i; 📌Yuqori harorat; 📌Bo‘yindagi…

#infografika «Suv havzalariga qoʻyiladigan gigiyenik talablar.» Sanepidqoʻmita Qarshi tuman boʻlimi Axborot xizmati https://t.me/sanepidqom_qarshitum
❓Kuydirgi kasalligini odamlarga yuqishini oldini olish uchun qanday qoidalarga qat’iy rioya qilish kerak? ✅xonadonlarda boqilayotgan chorva mollarini hududiy veterinariya vrachlari tomonidan kuydirgi kasalligiga qarshi har yili bir marotaba albatta emlatish zarur; ✅chorva mollarini uy sharoitida so‘yish taqiqlangan. Ularni faqat qushxonalarda…

📌Korrupsiya – jamiyat taraqqiyoti kushandasi! 📌Korrupsiya bu – mansab mavqeidan shaxsiy maqsadlarda foydalanish bilan bog‘liq bo‘lgan jinoyat turi hisoblanadi. Korrupsiya faoliyati xufyona iqtisodiyotning asosiy turlaridan biridir. Aksariyat hollarda korrupsiya deganda davlat xizmatchilari tomonidan shaxsiy manfaatlarni ko‘zlab, boylik orttirish maqsadida xalqdan…
❓Belgilanmagan joylarda choʻmilish inson salomatligi uchun qanchalik xavfli? ✅Belgilanmagan joylarda suvning tozalik darajasi noma’lum bo’lishi mumkin. Bu erda mikroblar, viruslar yoki boshqa zararlilar bo’lishi, infeksiyalarni tarqatishi xavfi mavjud. ✅Belgilanmagan joylar ko’pincha suvning chuqurligi va oqimini hisobga olmasdan cho’milish uchun qulay…

🔶Pnevmoniya (Zotiljam) o‘pka to‘qimasining barcha tarkibiy qismlarini zararlaydigan infeksion-yallig‘lanish kasalligidir. Bunda balg‘am bilan kuchli yo‘tal, ko‘krak qafasida og‘riq, holsizlik, tana haroratining keskin ko‘tarilishi va terlash kuzatiladi. 🔶Sabablari 🔶Pnevmoniya qo‘zg‘atuvchi mikroorganizmlar tufayli yuzaga keladi. Xavf quyidagi omillar mavjud bo‘lganda ortadi: 🔶Dekompensatsiya bosqichidagi…

Virusli gepatit B yuqish yo‘llari ✅Kasallanishning asosiy qismi zararlangan asboblar bilan (shprislar, ninalar, stomatologik asboblar va boshqalar), kam qismi HBV ga tekshirilmagan qon preparatlarini quyish bilan bog‘liq. Bundan tashqari yaqin muloqotda (ona-bola), jinsiy aloqada, shuningdek teri va shilliq qavatlarning shikastlanishi…
